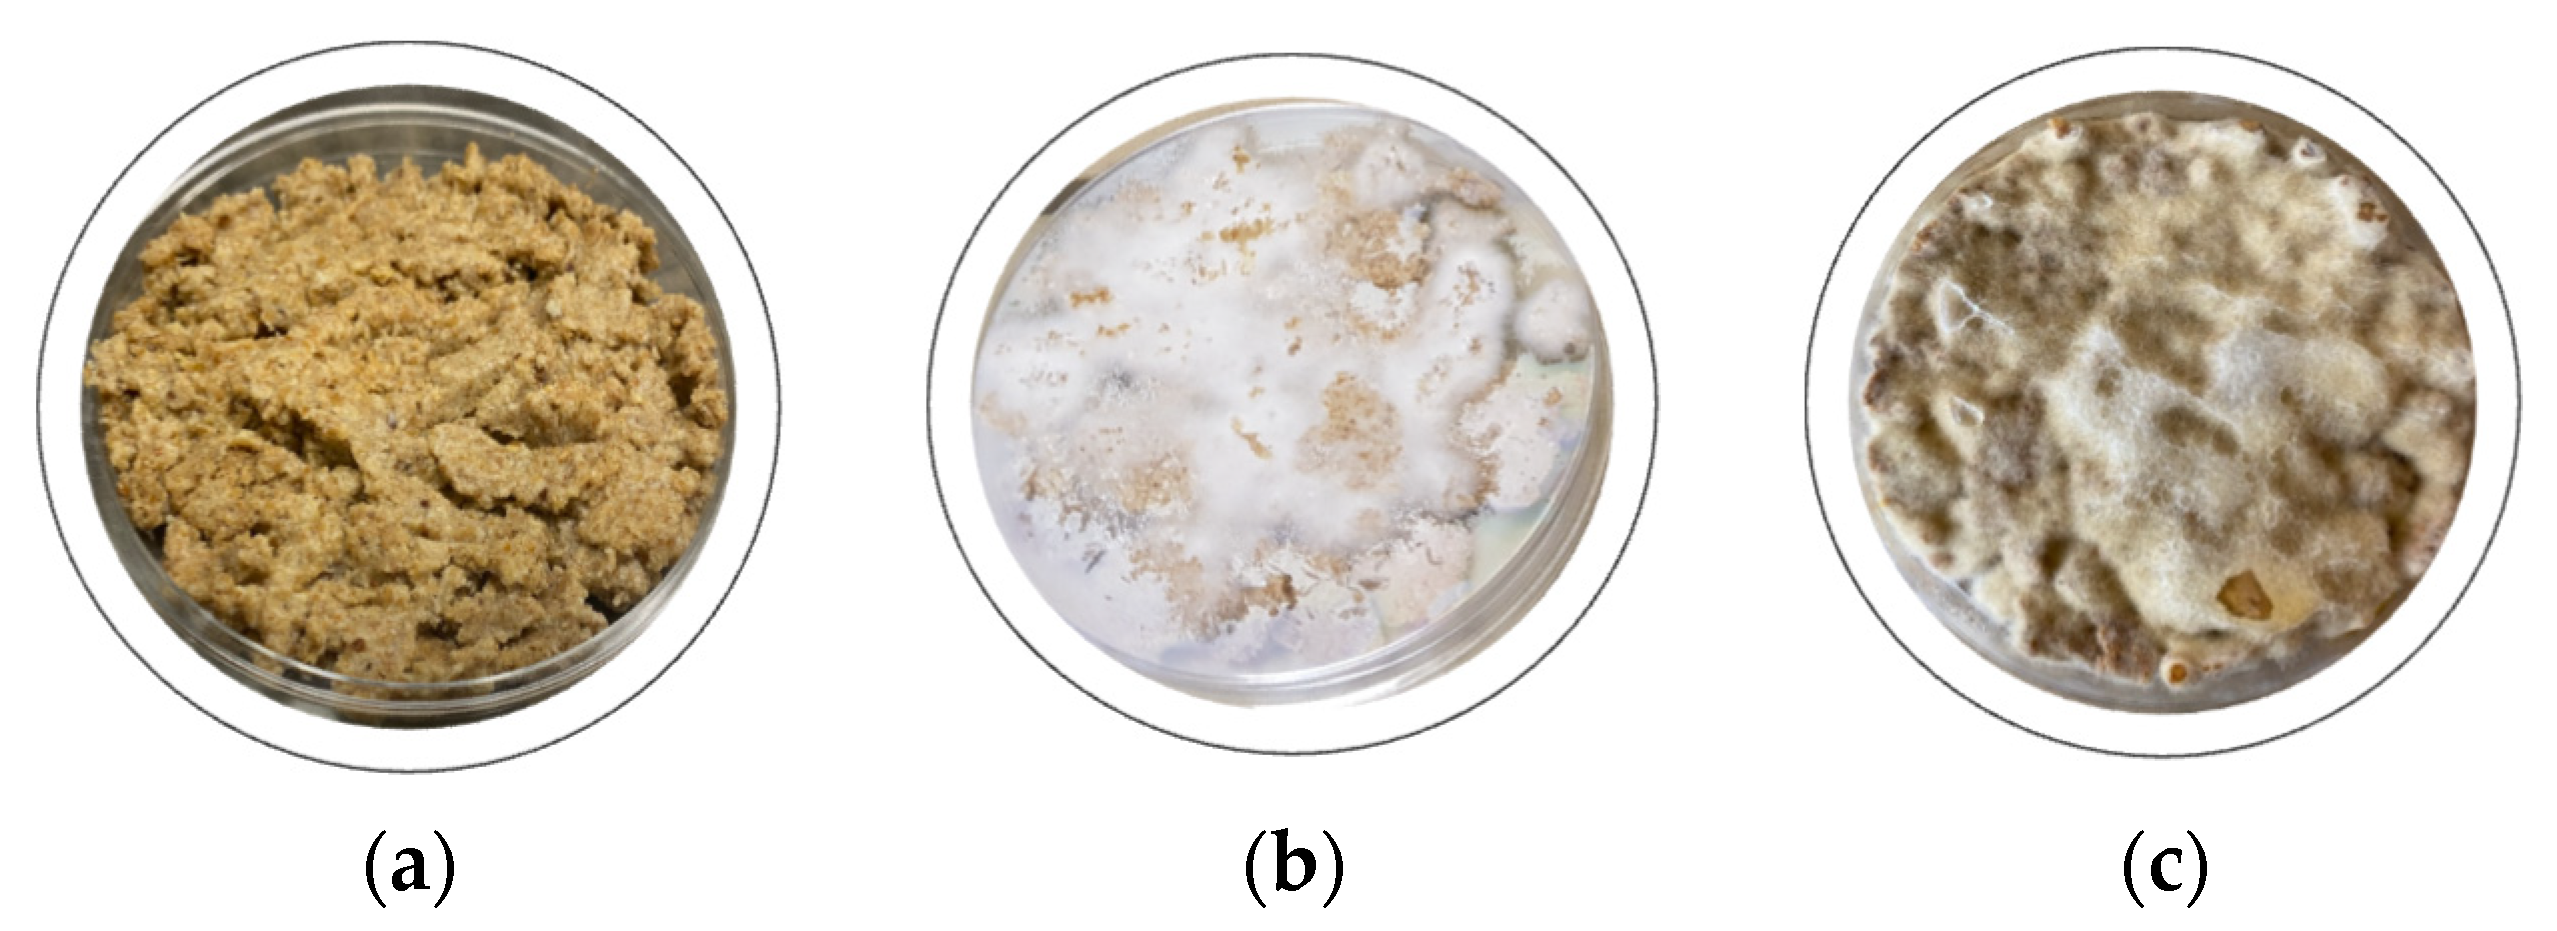
Sustainability 16 09936 g005 Sustainability 16 09936 g005

Sustainable Use of By-Products (Okara and Linseed Cake) in Tempeh Fermentation: Effects on Isoflavones and Lignans
Abstract
1. Introduction
2. Materials and Methods
2.1. Materials
2.2. Methods
2.2.1. Okara Preparation
2.2.2. Hydrothermal Treatment
2.2.3. Tempeh Fermentation
2.2.4. Culinary Treatment
2.2.5. Isoflavones Analysis
2.2.6. Secoisolariciresinol Diglucoside (SDG) Analysis
2.2.7. Statistical Analysis
3. Results and Discussion
3.1. Technological Treatment
3.2. Fermentation
3.3. Isoflavone Analysis
| Raw Soybean | Okara | R.o. NRRL 2710 24 h | R.o. NRRL 2710 48 h | RAGI 24 h | RAGI 48 h | |
|---|---|---|---|---|---|---|
| Daidzin | 8.73 ± 0.12 b | 28.49 ± 0.19 a | 2.77 ± 0.13 de | 8.56 ± 1.74 b | 5.47 ± 1.26 c | 3.17 ± 0.26 d |
| Glycitin | 3.55 ± 0.29 b | 5.09 ± 0.16 a | 2.29 ± 0.09 de | 3.08 ± 0.13 bc | 2.43 ± 0.71 cd | 2.19 ± 0.17 de |
| Malonyldaidzin | 53.42 ± 1.03 a | 48.93 ± 0.66 a | 21.04 ± 2.3 b | 20.95 ± 2.83 b | 15.66 ± 3.93 bc | 11.19 ± 0.78 cd |
| Malonylglycitin | 0 ± 0 e | 8.38 ± 0.06 a | 5.81 ± 0.18 b | 5.16 ± 0.41 b | 5.16 ± 0.78 b | 0 ± 0 e |
| Genistin | 13.26 ± 0.23 b | 40.82 ± 0.13 a | 3.97 ± 0.15 bcd | 12.96 ± 8 bc | 9.52 ± 3.06 bcd | 5.28 ± 0.17 bcd |
| Acetyldaidzin | 0 ± 0 d | 0 ± 0 d | 0 ± 0 d | 0 ± 0 d | 0 ± 0 d | 0 ± 0 d |
| Acetylglycitin | 7.65 ± 0.15 a | 0 ± 0 c | 4.63 ± 0.35 b | 0 ± 0 c | 0 ± 0 c | 0 ± 0 c |
| Malonylgenistin | 87.03 ± 2.55 b | 100.62 ± 0.3 a | 33.44 ± 1.5 c | 40.37 ± 4.39 c | 31.65 ± 8.33 c | 15.72 ± 3.4 d |
| Acetylgenistin | 4.55 ± 0.15 cd | 9.24 ± 0.65 a | 3.91 ± 0.05 d | 6.83 ± 0.69 b | 6.43 ± 0.51 bc | 5.27 ± 0.63 bcd |
| Daidzein | 4.52 ± 0.12 d | 8.53 ± 0.51 d | 18.49 ± 1.42 c | 17.92 ± 4.2 c | 27.73 ± 2.13 b | 50.03 ± 2.95 a |
| Glycitein | 0 ± 0 f | 1.04 ± 0.19 e | 1.92 ± 0.12 cd | 2.08 ± 0.46 c | 3.66 ± 0.12 b | 5.96 ± 0.37 a |
| Genistein | 2.88 ± 0.02 g | 80.52 ± 0.36 def | 128.99 ± 5.75 cd | 179.96 ± 46.83 c | 341.46 ± 16.13 b | 575.41 ± 10.95 a |
| Total | 185.6 ± 3.3 d | 331.7 ± 0.9 bc | 227.2 ± 12.9 c | 297.9 ± 43.3 bc | 449.2 ± 28.1 b | 674.2 ± 14 a |
| Fried R.o. NRRL 2710 24 h | Fried R.o. NRRL 2710 48 h | Fried RAGI 24 h | Fried RAGI 48 h | |
|---|---|---|---|---|
| Daidzin | 2.67 ± 0.31 def | 0.38 ± 0.01 ef | 1.94 ± 0.11 def | 0 ± 0 f |
| Glycitin | 1.47 ± 0.07 ef | 0.91 ± 0 fg | 1.23 ± 0 f | 0 ± 0 g |
| Malonyldaidzin | 7.61 ± 0.17 de | 4.53 ± 0.09 de | 9.17 ± 0.51 cde | 2.2 ± 3.11 e |
| Malonylglycitin | 2.36 ± 0.05 cd | 1.53 ± 0.09 d | 2.82 ± 0.07 c | 0 ± 0 e |
| Genistin | 4.29 ± 0.75 bcd | 0.23 ± 0 d | 3.5 ± 0.34 cd | 0.16 ± 0 d |
| Acetyldaidzin | 7.14 ± 0.58 a | 2.02 ± 0.02 c | 3.73 ± 0.82 b | 0 ± 0 d |
| Acetylglycitin | 4.43 ± 0.13 b | 3.9 ± 0.04 b | 4.64 ± 0.04 b | 0 ± 0 c |
| Malonylgenistin | 8.79 ± 0.67 de | 1.77 ± 0.2 e | 13.58 ± 0.36 de | 1.62 ± 0.02 e |
| Acetylgenistin | 9.16 ± 0.84 a | 3.36 ± 1.16 de | 5.61 ± 0.12 bcd | 1.25 ± 1.76 e |
| Daidzein | 5.79 ± 0.39 d | 2.86 ± 0.3 d | 9.45 ± 1.04 d | 4.55 ± 0.07 d |
| Glycitein | 0.83 ± 0.04 ef | 0 ± 0 f | 1.27 ± 0.16 de | 0.8 ± 0.02 ef |
| Genistein | 36.37 ± 5.04 efg | 14.08 ± 3.73 fg | 91.39 ± 17.02 de | 30.17 ± 0.11 efg |
| Total | 90.9 ± 8.9 e | 35.6 ± 4.6 f | 148.3 ± 16.7 g | 40.8 ± 4.9 g |
3.3.1. Fermentation Effect
3.3.2. Impact of Culinary Treatment
3.4. Secoisolariciresinol Diglycoside (SDG) Level
4. Conclusions
Author Contributions
Funding
Institutional Review Board Statement
Informed Consent Statement
Data Availability Statement
Acknowledgments
Conflicts of Interest
References
- Vong, W.C.; Liu, S.Q. Biovalorisation of okara (soybean residue) for food and nutrition. Trends Food Sci. Technol. 2016, 52, 139–147. [Google Scholar] [CrossRef]
- Ginting, E.; Elisabeth, D.A.A.; Khamidah, A.; Rinaldi, J.; Ambarsari, I.; Antarlina, S.S. The nutritional and economic potential of tofu dreg (okara) and its utilization for high protein food products in Indonesia. J. Agric. Food Res. 2024, 16, 101175. [Google Scholar] [CrossRef]
- Chen, P.-C.; Lin, C.; Chen, M.-H.; Chiang, P.-Y. The micronization process for improving the dietary value of okara (soybean residue) by planetary ball milling. LWT Food Sci. Technol. 2020, 132, 109848. [Google Scholar] [CrossRef]
- Jankowiak, L.; Trifunovic, O.; Boom, R.M.; Van Der Goot, A.J. The potential of crude okara for isoflavone production. J. Food Eng. 2014, 124, 166–172. [Google Scholar] [CrossRef]
- Privatti, R.T.; Capellini, M.C.; Aracava, K.K.; Pugine, S.M.P.; de Melo, M.P.; Rodrigues, C.E.C. Saline as solvent and ethanol-based purification process for the extraction of proteins and isoflavones from wet okara. Food Chem. 2024, 443, 138605. [Google Scholar] [CrossRef]
- Guimarães, R.M.; Silva, T.E.; Lemes, A.C.; Boldrin, M.C.F.; da Silva, M.A.P.; Silva, F.G.; Egea, M.B. Okara: A soybean by-product as an alternative to enrich vegetable paste. LWT Food Sci. Technol. 2018, 92, 593–599. [Google Scholar] [CrossRef]
- Canaan, J.M.M.; Brasil, G.S.A.P.; de Barros, N.R.; Mussagy, C.U.; Guerra, N.B.; Herculano, R.D. Soybean processing wastes and their potential in the generation of high value added products. Food Chem. 2022, 373, 131476. [Google Scholar] [CrossRef]
- Privatti, R.T.; Capellini, M.C.; Thomazini, M.; Favaro-Trindade, C.S.; Rodrigues, C.E.C. Profile and content of isoflavones on flaked and extruded soybeans and okara submitted to different drying methods. Food Chem. 2022, 380, 132168. [Google Scholar] [CrossRef]
- Hu, C.Y.; Chiu, M.C.; Christianty, R.A.; Chen, Y.C. Enrichment of functional characteristics in the okara by the fermentation of Rhizopus azygosporus. Waste Biomass Valorization 2022, 13, 2531–2538. [Google Scholar] [CrossRef]
- Mbow, C.; Rosenzweig, C.; Barioni, L.G.; Benton, T.G.; Shukla, P.R.; Skea, J.; Calvo Buendia, E.; Masson-Delmotte, V.; Pörtner, H.-O.; Roberts, D.C.; et al. Chapter 5: Food Security. In Climate Change and Land—An IPCC Special Report on Climate Change, Desertification, Land Degradation, Sustainable Land Management, Food Security, and Greenhouse Gas Fluxes in Terrestrial Ecosystems; IPCC: Geneva, Switzerland, 2019. [Google Scholar]
- The Royal Society. Future Food: Health and Sustainability—Conference Report; The Royal Society: London, UK, 2019. [Google Scholar]
- Chan, Y.H.; Lau, K.K.; Yiu, K.H.; Siu, C.W.; Chan, H.T.; Li, S.W.; Tam, S.; Lam, T.H.; Lau, C.P.; Tse, H.F. Prospective observational study of isoflavone and the risk of stroke recurrence: Potential clinical implications beyond vascular function. J. Nutr. Health Aging 2012, 16, 383–388. [Google Scholar] [CrossRef]
- Mahmoud, A.M.; Yang, W.; Bosland, M.C. Soy isoflavones and prostate cancer: A review of molecular mechanisms. J. Steroid Biochem. Mol. Biol. 2014, 140, 116–132. [Google Scholar] [CrossRef] [PubMed]
- Nagata, C.; Takatsuka, N.; Kawakami, N.; Shimizu, H. Soy product intake and hot flashes in japanese women: Results from a community-based prospective study. Am. J. Epidemiol. 2001, 153, 790–793. [Google Scholar] [CrossRef] [PubMed]
- Murkies, A.L.; Lombard, C.; Strauss, B.J.G.; Wilcox, G.; Burger, H.G.; Morton, M.S. “Reprint of” dietary flour supplementation decreases post-menopausal hot flushes: Effect of soy and wheat. Maturitas 2008, 61, 27–33. [Google Scholar] [CrossRef] [PubMed]
- Tempfer, C.B.; Bentz, E.K.; Leodolter, S.; Tscherne, G.; Reuss, F.; Cross, H.S.; Huber, J.C. Phytoestrogens in clinical practice: A review of the literature. Fertil. Steril. 2007, 87, 1243–1249. [Google Scholar] [CrossRef] [PubMed]
- Messina, M.; Mejia, S.B.; Cassidy, A.; Duncan, A.; Kurzer, M.; Nagato, C.; Ronis, M.; Rowland, I.; Sievenpiper, J.; Barnes, S. Neither soyfoods nor isoflavones warrant classification as endocrine disruptors: A technical review of the observational and clinical data. Crit. Rev. Food Sci. Nutr. 2021, 62, 5824–5885. [Google Scholar] [CrossRef]
- Murphy, P.A.; Barua, K.; Hauck, C.C. Solvent extraction selection in the determination of isoflavones in soy foods. J. Chromatogr. B 2002, 777, 129–138. [Google Scholar] [CrossRef]
- Chang, Y.; Choue, R. Plasma pharmacokinetics and urinary excretion of isoflavones after ingestion of soy products with different aglycone/glucoside ratios in South Korean women. Nutr. Res. Pract. 2013, 7, 393–399. [Google Scholar] [CrossRef]
- Lambert, M.N.T.; Hu, L.M.; Jeppesen, P.B. A Systematic review and meta-analysis of the effects of isoflavone formulations against estrogen-deficient bone resorption in peri- and postmenopausal women. Am. J. Clin. Nutr. 2017, 106, 801–812. [Google Scholar] [CrossRef]
- Lu, L.J.W.; Chen, N.W.; Nayeem, F.; Nagamani, M.; Anderson, K.E. Soy isoflavones interact with calcium and contribute to blood pressure homeostasis in women: A randomized, double-blind, placebo controlled trial. Eur. J. Nutr. 2020, 59, 2369–2381. [Google Scholar] [CrossRef]
- Fernandez-Lopez, A.; Lamothe, V.; Delample, M.; Denayrolles, M.; Bennetau-Pelissero, C. Removing isoflavones from modern soyfood: Why and how? Food Chem. 2016, 210, 286–294. [Google Scholar] [CrossRef]
- Bennetau-Pelissero, C. Response to the letter from Dr Messina and Dr Badger following the publication of the paper by Fernandez-Lopez A, Lamothe V, Delample M, Denayrolles M and Bennetau-Pelissero C. Entitled: Removing isoflavones from modern soyfood: Why and how? Food Chem. 2017, 225, 293–301. [Google Scholar] [CrossRef] [PubMed]
- Ohfuji, S.; Fukushima, W.; Watanabe, K.; Sasaki, S.; Yamagami, H.; Nagahori, M.; Watanabe, M.; Hirota, Y. Pre-illness isoflavone consumption and disease risk of ulcerative colitis: A multicenter case-control study in Japan. PLoS ONE 2014, 9, e110270. [Google Scholar] [CrossRef] [PubMed]
- Tsuchiya, M.; Hama, M.; Nagata, S.; Kawamoto, A.; Suzuki, K.; Shimizu, H.; Anzai, S.; Takahashi, J.; Kuno, R.; Takeoka, S.; et al. Functional analysis of isoflavones using patient-derived human colonic organoids. Biochem. Biophys. Res. Commun. 2021, 542, 40–47. [Google Scholar] [CrossRef] [PubMed]
- de Oliveira Silva, F.; Lemos, T.C.C.; Sandôra, D.; Monteiro, M.; Perrone, D. Fermentation of soybean meal improves isoflavone metabolism after soy biscuit consumption by adults. J. Sci. Food Agric. 2020, 100, 2991–2998. [Google Scholar] [CrossRef]
- Kumar, N.B.; Pow-Sang, J.; Spiess, P.; Dickinson, S.; Schell, M.J. A phase ii randomized clinical trial using aglycone isoflavones to treat patients with localized prostate cancer in the pre-surgical period prior to radical prostatectomy. Oncotarget 2020, 11, 1218–1234. [Google Scholar] [CrossRef]
- The 17 Goals—Sustainable Development. Available online: https://sdgs.un.org/goals (accessed on 24 September 2024).
- European Commission. Communication from the Commission to the European Parliament, the Council, the European Economic and Social Committee and the Committee of the Regions. Next Steps for a Sustainable European Future. European Action for Sustainability; European Commission: Strasbourg, Belgium, 2016.
- FAO; IFAD; WFP. The State of Food Insecurity in the World 2015: Meeting the 2015 International Hunger Targets: Taking Stock of Uneven Progress; FAO: Rome, Italy, 2015. [Google Scholar]
- FAO. How to Feed the World in 2050. Insights from an Expert Meeting at FAO, 2050; FAO: Rome, Italy, 2009; Volume 228. [Google Scholar]
- Shukla, P.R.; Skea, J.; Calvo Buendia, E.; Masson-Delmotte, V.; Pörtner, H.-O.; Roberts, D.C.; Zhai, P.; Slade, R.; Connors, S.; Van Diemen, R.; et al. Summary for Policymakers. In Climate Change and Land—An IPCC Special Report on Climate Change, Desertification, Land Degradation, Sustainable Land Management, Food Security, and Greenhouse Gas Fluxes in Terrestrial Ecosystems; IPCC: Geneva, Switzerland, 2019. [Google Scholar]
- Jasińska-Kuligowska, I.; Kuligowski, M. Quality of soy-based meat alternatives. In Current Trends in Quality Science—Design, Quality and Safety of Products; Klimczak, I., Ed.; Institute of Quality Science, Poznań University of Economics & Business: Poznań, Poland, 2021; pp. 381–382. ISBN 9788377896709. [Google Scholar]
- FAOSTAT. Available online: http://www.fao.org/faostat/en/#data/QC (accessed on 4 September 2024).
- Jasińska-Kuligowska, I.; Suszko, P.; Kuligowski, M. Wytłoki lniane jako źródło fitoestrogenów i innych związków bioaktywnych. In Składniki Bioaktywne Surowców i Produktów Roślinnych; Słupski, J., Tarko, T., Drożdż, I., Eds.; Polskie Towarzystwo Technologów Żywności Oddział Małopolski: Kraków, Poland, 2018; Volume 1, pp. 1–308. ISBN 978-83-946796-1-3. [Google Scholar]
- Feng, C.; Wu, Y.; Cai, Z.; Song, Z.; Shim, Y.Y.; Reaney, M.J.T.; Wang, Y.; Zhang, N. A comparative study on flaxseed lignan biotransformation through resting cell catalysis and microbial fermentation by β-glucosidase production lactiplantibacillus plantarum. J. Sci. Food Agric. 2024, 104, 5869–5881. [Google Scholar] [CrossRef]
- Katagiri, R.; Sawada, N.; Goto, A.; Yamaji, T.; Iwasaki, M.; Noda, M.; Iso, H.; Tsugane, S. Association of soy and fermented soy product intake with total and cause specific mortality: Prospective cohort study. BMJ 2020, 368, 1–12. [Google Scholar] [CrossRef]
- Hutchins, A.M.; Slavin, J.L.; Lampe, J.W. Urinary isoflavonoid phytoestrogen and lignan excretion after consumption of fermented and unfermented soy products. J. Am. Diet. Assoc. 1995, 95, 545–551. [Google Scholar] [CrossRef]
- Nout, M.J.R.; Kiers, J.L. Tempe fermentation, innovation and functionality: Update into the third millenium. J. Appl. Microbiol. 2005, 98, 789–805. [Google Scholar] [CrossRef]
- Ahnan-Winarno, A.D.; Cordeiro, L.; Winarno, F.G.; Gibbons, J.; Xiao, H. Tempeh: A semicentennial review on its health benefits, fermentation, safety, processing, sustainability, and affordability. Compr. Rev. Food Sci. Food Saf. 2021, 20, 1717–1767. [Google Scholar] [CrossRef]
- Kuligowski, M.; Pawłowska, K.; Jasińska-Kuligowska, I.; Nowak, J. Isoflavone composition, polyphenols content and antioxidative activity of soybean seeds during tempeh fermentation. CyTA J. Food 2017, 15, 27–33. [Google Scholar] [CrossRef]
- Achouri, A.; Boye, J.I.; Belanger, D. Soybean Isoflavones: Efficacy of extraction conditions and effect of food type on extractability. Food Res. Int. 2005, 38, 1199–1204. [Google Scholar] [CrossRef]
- Jasińska-Kuligowska, I. Zastosowanie Chromatografii Cieczowej Sprzężonej ze Spektrometrem mas (LC-MS) w Analizie Lignanów; Adam Mickiewicz Univeristy: Poznan, Poland, 2016. [Google Scholar]
- Waghmode, A.T.; Pandit, A.B.; Kale, D.M. Performance and energy saving analysis of improved cooking vessel. J. Res. Innov. Food Sci. Technol. 2023, 11, 383–396. [Google Scholar] [CrossRef]
- Duliński, R.; Stodolak, B.; Byczyński, Ł.; Poreda, A.; Starzyńska-Janiszewska, A.; Żyła, K. Solid-state fermentation reduces phytic acid level, improves the profile of myo-inositol phosphates and enhances the availability of selected minerals in flaxseed oil cake. Food Technol. Biotechnol. 2017, 55, 413–419. [Google Scholar] [CrossRef] [PubMed]
- Pérez–Velasco, R.; Gómez-Gil, B.; Martínez-Montaño, E.; González-Córdova, A.F.; Hernández, C. Nutritional attributes and microbial metagenomic profile during solid-state fermentation of soybean meal inoculated with lactobacillus acidophilus under non-sterile conditions. J. Sci. Food Agric. 2024, 104, 8219–8229. [Google Scholar] [CrossRef]
- Matsuo, M. Utilization of cooked and pasted okara-tempeh as an ingredient of pancake or croquette. J. Home Econ. Japan 2007, 58, 41–47. [Google Scholar] [CrossRef]
- Kuligowski, M.; Sobkowiak, D.; Polanowska, K.; Jasińska-Kuligowska, I. Effect of different processing methods on isoflavone content in soybeans and soy products. J. Food Compos. Anal. 2022, 110, 104535. [Google Scholar] [CrossRef]
- Chen, L.; Teng, H.; Xiao, J. A value-added cooking process to improve the quality of soybean: Protecting its isoflavones and antioxidant activity. Food Sci. Hum. Wellness 2019, 8, 195–201. [Google Scholar] [CrossRef]
- Han, J.S.; Hong, H.D.; Kim, S.R. Changes in isoflavone content and mass balance during soybean processing. Food Sci. Biotechnol. 2007, 16, 426–433. [Google Scholar]
- Muliterno, M.M.; Rodrigues, D.; de Lima, F.S.; Ida, E.I.; Kurozawa, L.E. Conversion/degradation of isoflavones and color alterations during the drying of okara. LWT Food Sci. Technol. 2017, 75, 512–519. [Google Scholar] [CrossRef]
- Chien, J.T.; Hsieh, H.C.; Kao, T.H.; Chen, B.H. Kinetic model for studying the conversion and degradation of isoflavones during heating. Food Chem. 2005, 91, 425–434. [Google Scholar] [CrossRef]
- Stintzing, F.C.; Hoffmann, M.; Carle, R. Thermal degradation kinetics of isoflavone aglycones from soy and red clover. Mol. Nutr. Food Res. 2006, 50, 373–377. [Google Scholar] [CrossRef] [PubMed]
- Lee, J.H.; Hwang, C.E.; Son, K.S.; Cho, K.M. Comparisons of nutritional constituents in soybeans during solid state fermentation times and screening for their glucosidase enzymes and antioxidant properties. Food Chem. 2019, 272, 362–371. [Google Scholar] [CrossRef] [PubMed]
- Qu, S.; Kwon, S.J.; Duan, S.; Lim, Y.J.; Eom, S.H. Isoflavone changes in immature and mature soybeans by thermal processing. Molecules 2021, 26, 7471. [Google Scholar] [CrossRef] [PubMed]
- Kasuga, A.; Ogiwara, E.; Aoyagi, Y.; Kimura, H. Changes in isoflavone content of soybeans during heating process. Nippon. Shokuhin Kagaku Kogaku Kaishi 2006, 53, 365–372. [Google Scholar] [CrossRef][Green Version]
- Bensaada, S.; Peruzzi, G.; Cubizolles, L.; Denayrolles, M.; Bennetau-Pelissero, C. Traditional and domestic cooking dramatically reduce estrogenic isoflavones in soy foods. Foods 2024, 13, 999. [Google Scholar] [CrossRef]
- Gerstenmeyer, E.; Reimer, S.; Berghofer, E.; Schwartz, H.; Sontag, G. Effect of thermal heating on some lignans in flax seeds, sesame seeds and rye. Food Chem. 2013, 138, 1847–1855. [Google Scholar] [CrossRef]

Disclaimer/Publisher’s Note: The statements, opinions and data contained in all publications are solely those of the individual author(s) and contributor(s) and not of MDPI and/or the editor(s). MDPI and/or the editor(s) disclaim responsibility for any injury to people or property resulting from any ideas, methods, instructions or products referred to in the content. |
© 2024 by the authors. Licensee MDPI, Basel, Switzerland. This article is an open access article distributed under the terms and conditions of the Creative Commons Attribution (CC BY) license (https://creativecommons.org/licenses/by/4.0/).
Share and Cite
Kuligowski, M.; Radziejewska-Kubzdela, E.; Górna, O.; Jasińska-Kuligowska, I.; Kidoń, M. Sustainable Use of By-Products (Okara and Linseed Cake) in Tempeh Fermentation: Effects on Isoflavones and Lignans. Sustainability 2024, 16, 9936. https://doi.org/10.3390/su16229936
Kuligowski M, Radziejewska-Kubzdela E, Górna O, Jasińska-Kuligowska I, Kidoń M. Sustainable Use of By-Products (Okara and Linseed Cake) in Tempeh Fermentation: Effects on Isoflavones and Lignans. Sustainability. 2024; 16(22):9936. https://doi.org/10.3390/su16229936
Chicago/Turabian StyleKuligowski, Maciej, Elżbieta Radziejewska-Kubzdela, Oliwia Górna, Iwona Jasińska-Kuligowska, and Marcin Kidoń. 2024. "Sustainable Use of By-Products (Okara and Linseed Cake) in Tempeh Fermentation: Effects on Isoflavones and Lignans" Sustainability 16, no. 22: 9936. https://doi.org/10.3390/su16229936
APA StyleKuligowski, M., Radziejewska-Kubzdela, E., Górna, O., Jasińska-Kuligowska, I., & Kidoń, M. (2024). Sustainable Use of By-Products (Okara and Linseed Cake) in Tempeh Fermentation: Effects on Isoflavones and Lignans. Sustainability, 16(22), 9936. https://doi.org/10.3390/su16229936






